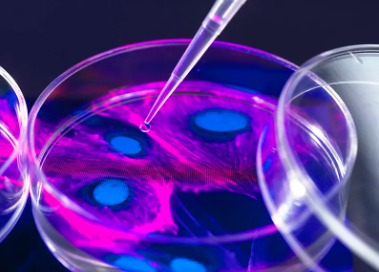
image.png

干細(xì)胞面部抗衰價格怎么樣?效果明顯嗎?
2024-10-24 11:15:27 來源: 小編 咨詢醫(yī)生
干細(xì)胞面部抗衰老技術(shù)作為一種前沿的抗衰方法,近年來備受關(guān)注。它利用干細(xì)胞的自我更新和分化能力,幫助修復(fù)和再生肌膚,從而達(dá)到抗衰老的效果。那么,干細(xì)胞面部抗衰的價格如何?效果又是否明顯呢?
一、干細(xì)胞面部抗衰價格
干細(xì)胞面部抗衰的價格受多種因素影響,包括地區(qū)、醫(yī)療機構(gòu)、治療方案和患者個體差異等。一般來說,以下因素會影響干細(xì)胞面部抗衰的價格:
1.地區(qū):不同地區(qū)的消費水平和醫(yī)療水平不同,價格也會有所差異。一般來說,一線城市的價格會高于二線和三線城市。
2.醫(yī)療機構(gòu):不同醫(yī)療機構(gòu)的收費標(biāo)準(zhǔn)不同,一般來說,知名度高、口碑好的醫(yī)療機構(gòu)價格會相對較高。
3.治療方案:干細(xì)胞面部抗衰的治療方案因人而異,包括干細(xì)胞注射、微針、儀器導(dǎo)入等。不同治療方案的價格也有所不同。
4.患者個體差異:患者年齡、膚質(zhì)、身體健康狀況等因素都會影響治療價格。
綜合來看,干細(xì)胞面部抗衰的價格一般在幾千元到幾萬元不等。具體價格需要根據(jù)實際情況和醫(yī)療機構(gòu)進(jìn)行咨詢。
二、干細(xì)胞面部抗衰效果
干細(xì)胞面部抗衰老的效果是明顯的,主要體現(xiàn)在以下幾個方面:
1.修復(fù)損傷:干細(xì)胞具有強大的修復(fù)損傷能力,可以修復(fù)受損的皮膚細(xì)胞,改善肌膚狀況。
2.促進(jìn)新生:干細(xì)胞能促進(jìn)皮膚新生,增加皮膚厚度,提高肌膚彈性和緊致度。
3.改善膚質(zhì):干細(xì)胞面部抗衰老能改善肌膚光澤、細(xì)膩度和水潤度,使肌膚更加年輕。
4.提拉緊致:干細(xì)胞面部抗衰老能**膠原蛋白的產(chǎn)生,從而達(dá)到提拉緊致的效果。
5.持久效果:與傳統(tǒng)的護(hù)膚品和美容儀器相比,干細(xì)胞面部抗衰老具有持久的效果,一般可以維持1-2年。
需要注意的是,干細(xì)胞面部抗衰老的效果與個體差異有關(guān),不同患者的治療效果可能有所不同。此外,治療過程中的護(hù)理和保養(yǎng)也是影響效果的重要因素。
總之,干細(xì)胞面部抗衰老技術(shù)在抗衰老領(lǐng)域具有很高的應(yīng)用價值。在選擇干細(xì)胞面部抗衰老治療時,患者應(yīng)充分了解價格和效果,并選擇正規(guī)醫(yī)療機構(gòu)進(jìn)行治療,以確保安全有效。
- 2024-10-12干細(xì)胞抗衰老真的有效嗎?哪些方法最被認(rèn)可?
- 2024-11-06干細(xì)胞抗衰老項目介紹與效果?
- 2024-08-01干細(xì)胞美容效果,干細(xì)胞美容有什么副作用
- 2024-09-22干細(xì)胞抗衰產(chǎn)品運營模式分析
- 2024-12-07用干細(xì)胞抗衰老治療的弊端有哪些,如何規(guī)避這些風(fēng)險
- 2024-10-17干細(xì)胞異體注射抗衰老的原理與作用
- 2024-09-11干細(xì)胞抗衰老最新成果,這些方面取得重大突破
- 2024-09-22干細(xì)胞療法騙局曝光,干細(xì)胞療法可靠嗎
- 2024-09-24陜西生物干細(xì)胞存儲公司有哪些
- 2024-07-18打干細(xì)胞要打幾次才有效果,注射干細(xì)胞的功效作用及次數(shù)介紹
- 2024-09-16干細(xì)胞恢復(fù)卵巢費用多少錢,恢復(fù)原理方法詳解
- 2024-10-07南通干細(xì)胞作用有哪些?與本地醫(yī)療機構(gòu)有何合作?
- 2024-07-27蘋果干細(xì)胞抗衰面膜,蘋果干細(xì)胞能去皺嗎
- 2024-08-16造血干細(xì)胞來源,造血干細(xì)胞的三個來源
- 2024-08-03造血干細(xì)胞分化,造血干細(xì)胞移植費用
- 2024-09-30干細(xì)胞填充眼袋凹陷效果好不好,與傳統(tǒng)方法有何區(qū)別
- 2024-08-22間充質(zhì)干細(xì)胞一針多少錢,能維持多久
- 2024-09-27日本干細(xì)胞抗衰老真的有效嗎?有沒有風(fēng)險?
